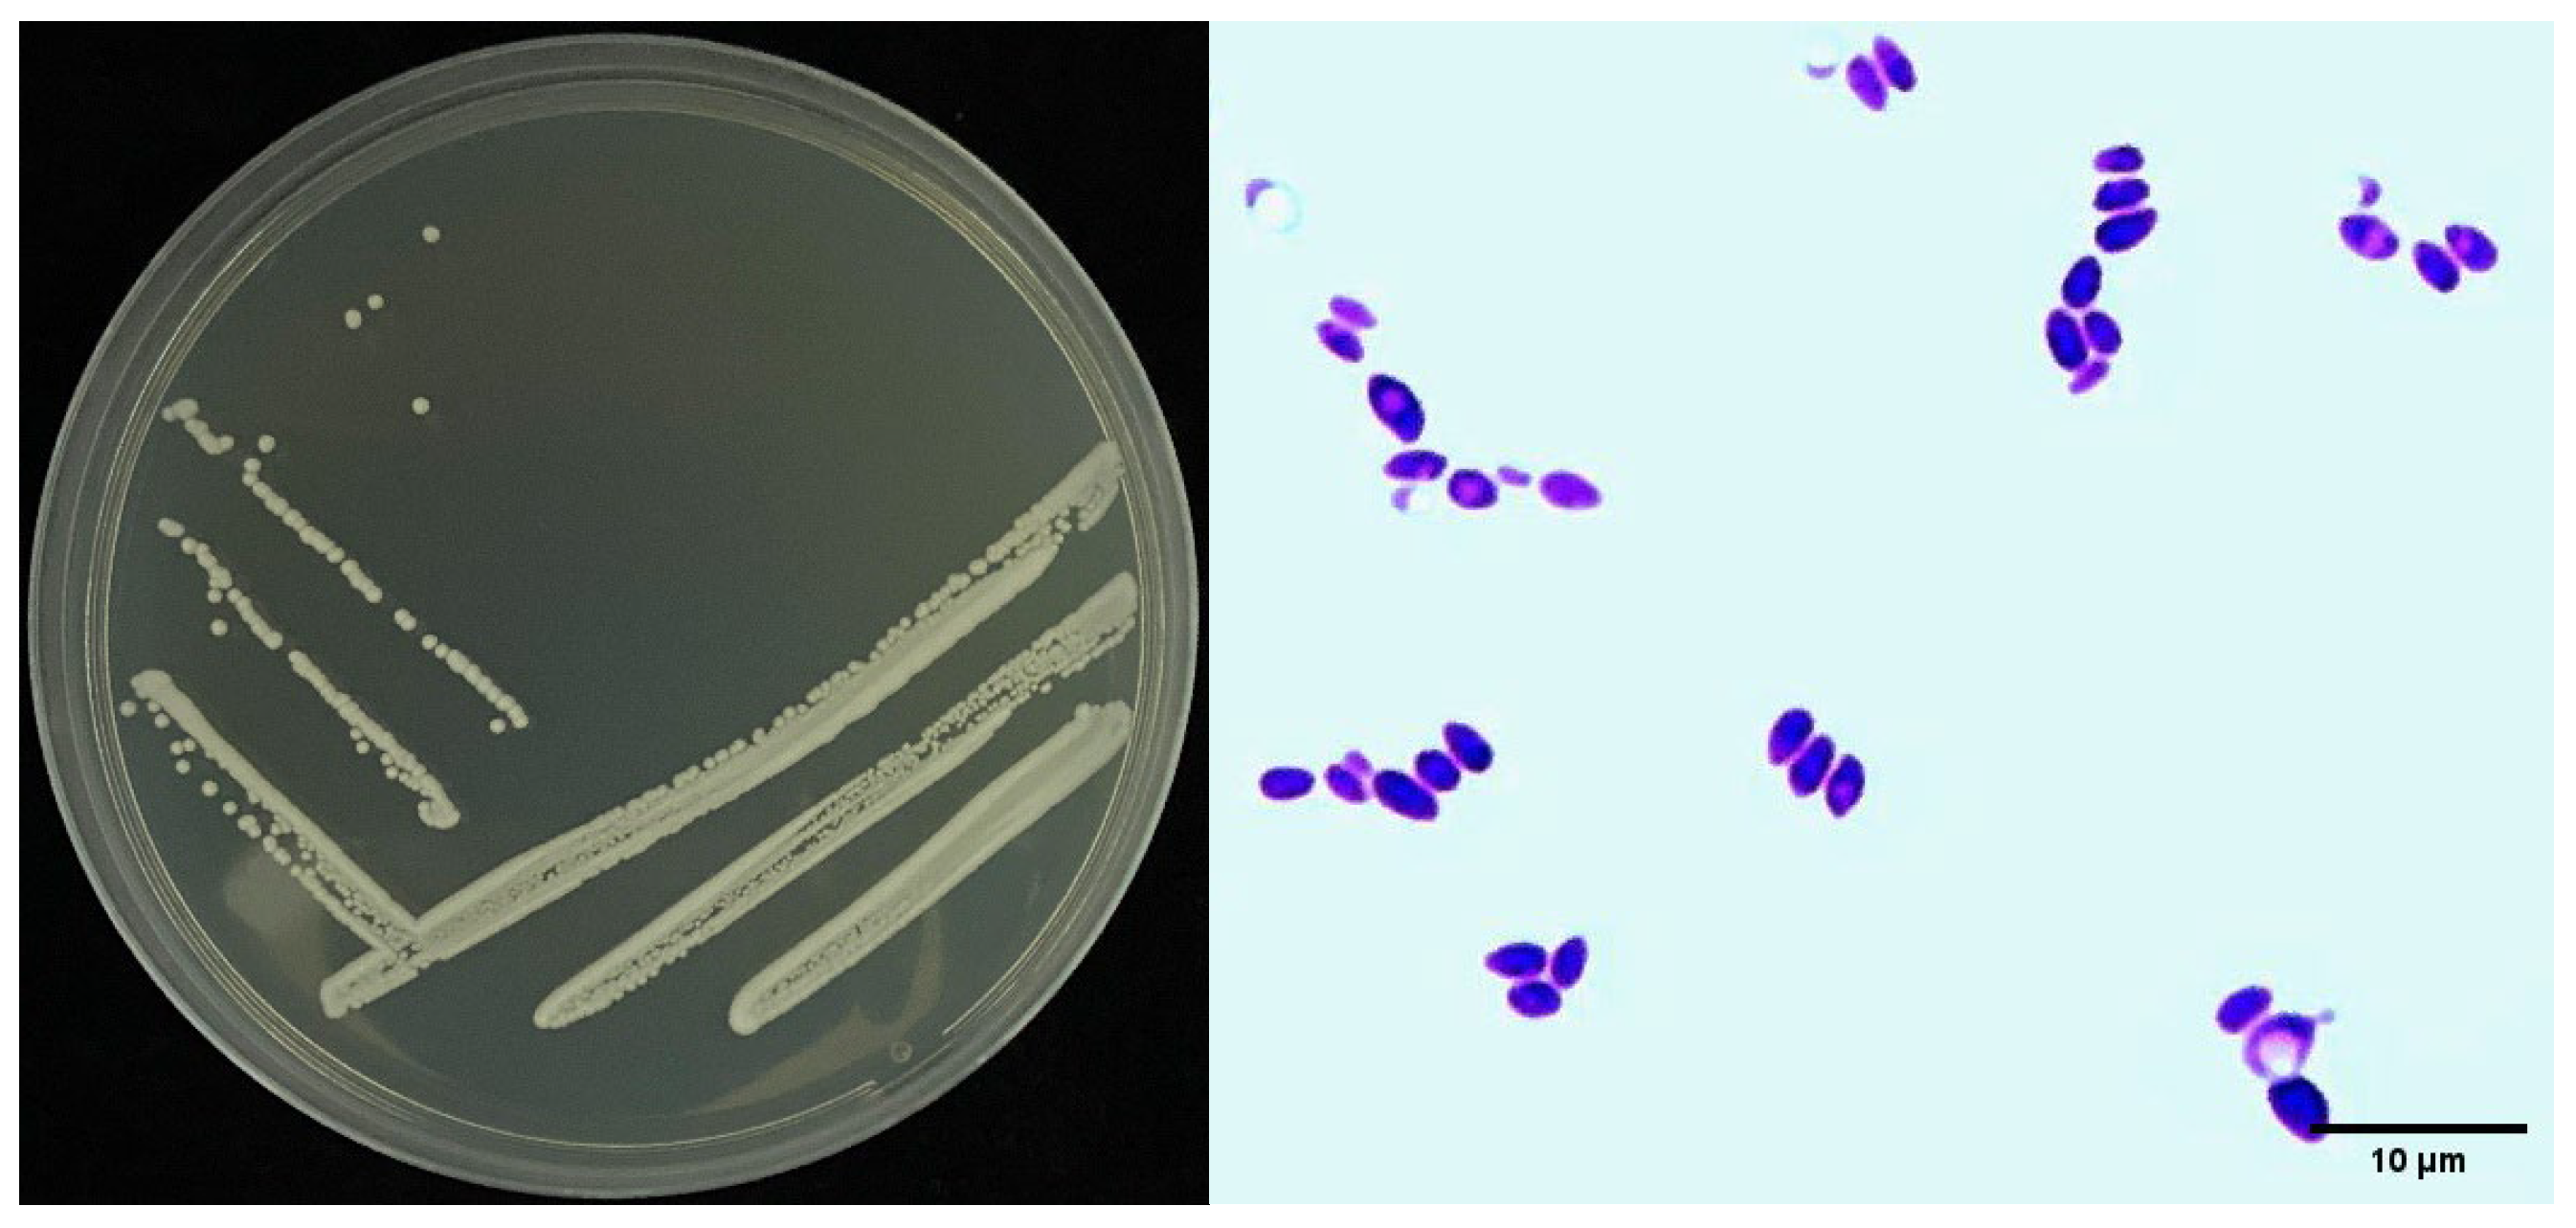
Biology 11 01724 g002 Biology 11 01724 g002

Isolation and Characterization of Novel Biological Control Agent Clostridium beijerinckii against Meloidogyne incognita
Abstract
Simple Summary
Abstract
1. Introduction
2. Materials and Methods
2.1. Preparation of Bacterial Strain Culture and Nematodes
2.2. Preliminary Screening on Mortality of Juveniles and Egg Hatchability Treated by Bacterial Strain Filtrate
2.3. Second Screening of Sneb518 on Mortality and Egg Hatchability In Vitro
2.4. Identification of Strain Sneb518
2.5. Sneb518′s Effect on Tomato Seedling Growth
2.6. Effect of Sneb518 against M. incognita in the Pot Experiments
2.7. Statistical Analysis
3. Results
3.1. Preliminary Screening on Mortality of Juveniles and Egg Hatching Treated by Bacterial Strains In Vitro
3.2. Second Screening of Sneb518 for Nematode Mortality and Egg Hatchability
3.3. Identification of Strain Sneb518
3.4. Sneb518′s Effect on Tomato Seedling Growth
3.5. Effect of Sneb518 on the Control of M. incognita in the Pot Experiments
4. Discussion
5. Conclusions
Author Contributions
Funding
Institutional Review Board Statement
Informed Consent Statement
Data Availability Statement
Conflicts of Interest
References
- Abd-Elgawad, M.M.; Askary, T.H. Impact of Phytonematodes on Agriculture Economy; CABI: Wallingford, UK, 2015. [Google Scholar]
- Sikandar, A.; Khanum, T.A.; Wang, Y. Biodiversity and community analysis of plant-parasitic and free-living nematodes associated with maize and other rotational crops from Punjab, Pakistan. Life 2021, 11, 1426. [Google Scholar] [CrossRef]
- Kim, T.Y.; Jang, J.Y.; Jeon, S.J.; Lee, H.W.; Bae, C.-H.; Yeo, J.H.; Lee, H.B.; Kim, I.S.; Park, H.W.; Kim, J.-C. Nematicidal activity of kojic acid produced by Aspergillus oryzae against Meloidogyne incognita. J. Microbiol. Biotechnol. 2016, 26, 1383–1391. [Google Scholar] [CrossRef]
- Sikandar, A.; Zhang, M.; Wang, Y.; Zhu, X.; Liu, X.; Fan, H.; Xuan, Y.; Chen, L.; Duan, Y. In vitro evaluation of Penicillium chrysogenum Snef1216 against Meloidogyne incognita (root-knot nematode). Sci. Rep. 2020, 10, 8342. [Google Scholar] [CrossRef] [PubMed]
- Sikandar, A.; Zhang, M.; Wang, Y.; Zhu, X.; Liu, X.; Fan, H.; Xuan, Y.; Chen, L.; Duan, Y. Review article: Meloidogyne incognita (root-knot nemtaode) a risk to agriculture. Appl. Ecol. Environ. Res. 2020, 18, 1679–1690. [Google Scholar] [CrossRef]
- Nyaku, S.T.; Affokpon, A.; Danquah, A.; Brentu, F.C. Harnessing useful rhizosphere microorganisms for nematode control. In Nematology-Concepts, Diagnosis and Control; Shah, M.M., Mahamood, M., Eds.; IntechOpen: London, UK, 2017; p. 153. [Google Scholar]
- Pulavarty, A.; Egan, A.; Karpinska, A.; Horgan, K.; Kakouli-Duarte, T. Plant parasitic nematodes: A review on their behaviour, host interaction, management approaches and their occurrence in two sites in the Republic of Ireland. Plants 2021, 10, 2352. [Google Scholar] [CrossRef] [PubMed]
- Bahadur, A. Nematodes diseases of fruits and vegetables crops in India. In Nematodes-Recent Advances, Management and New Perspectives; Bellé, C., Kaspary, T.E., Eds.; IntechOpen: London, UK, 2021; pp. 1–18. [Google Scholar]
- Rusinque, L.; Nóbrega, F.; Cordeiro, L.; Lima, A.; Andrade, S.; Inácio, M.L. Root-knot nematode species associated with horticultural crops in the Island of Azores, Portugal. Horticulturae 2022, 8, 101. [Google Scholar] [CrossRef]
- Sikandar, A.; Zhang, M.; Yang, R.; Liu, D.; Zhu, X.; Liu, X.; Fan, H.; Duan, Y.; Wang, Y. Analysis of gene expression in cucumber roots interacting with Penicillium chrysogenum strain Snef1216 through seed coating, which induced resistance to Meloidogyne incognita. Nematology 2021, 24, 121–135. [Google Scholar] [CrossRef]
- Na, J.; Hui, X.; Li, W.-J.; Wang, X.-Y.; Qian, L.; Liu, S.-S.; Pei, L.; Zhao, J.-L.; Heng, J. Field evaluation of Streptomyces rubrogriseus HDZ-9-47 for biocontrol of Meloidogyne incognita on tomato. J. Integr. Agric. 2017, 16, 1347–1357. [Google Scholar]
- Onkendi, E.M.; Kariuki, G.M.; Marais, M.; Moleleki, L.N. The threat of root-knot nematodes (Meloidogyne spp.) in A frica: A review. Plant Pathol. 2014, 63, 727–737. [Google Scholar] [CrossRef]
- Mwamula, A.O.; Kabir, M.F.; Lee, D. A review of the potency of plant extracts and compounds from key families as an alternative to synthetic nematicides: History, efficacy, and current developments. Plant Pathol. J. 2022, 38, 53–77. [Google Scholar] [CrossRef]
- Abd-Elgawad, M. Biological control agents of plant-parasitic nematodes. Egypt. J. Biol. Pest Control 2016, 26, 423–429. [Google Scholar]
- Sharma, A.; Diwevidi, V.; Singh, S.; Pawar, K.K.; Jerman, M.; Singh, L.; Singh, S.; Srivastawav, D. Biological control and its important in agriculture. Int. J. Biotechnol. Bioeng. Res. 2013, 4, 175–180. [Google Scholar]
- Sikandar, A.; Zhang, M.; Zhu, X.; Wang, Y.; Ahmed, M.; Iqbal, M.; Javeed, A.; Xuan, Y.; Fan, H.; Liu, X. Efficacy of Penicillium chrysogenum strain SNEF1216 against root-knot nematodes (Meloidogyne incognita) in cucumber (Cucumis sativus L.) under greenhouse conditions. Appl. Ecol. Environ. Res. 2019, 17, 12451–12464. [Google Scholar] [CrossRef]
- Hu, H.; Gao, Y.; Li, X.; Chen, S.; Yan, S.; Tian, X. Identification and nematicidal characterization of proteases secreted by endophytic bacteria Bacillus cereus BCM2. Phytopathol. 2020, 110, 336–344. [Google Scholar] [CrossRef]
- Abd-Elgawad, M.M.; Askary, T.H. Fungal and bacterial nematicides in integrated nematode management strategies. Egypt. J. Biol. Pest Control 2018, 28, 74. [Google Scholar] [CrossRef]
- Khan, N.F.; Rasool, A.; Mansoor, S.; Saleem, S.; Baba, T.R.; Haq, S.M.; Rehman, S.A.; Adetunji, C.O.; Popescu, S.M. Potential applications of rhizobacteria as eco-friendly biological control, plant growth promotion and soil metal bioremediation. In Sustainable Crop Production; Meena, V., Choudhary, M., Yadav, R.P., Meena, S.K., Eds.; IntechOpen: London, UK, 2022. [Google Scholar]
- Tian, B.; Yang, J.; Zhang, K.-Q. Bacteria used in the biological control of plant-parasitic nematodes: Populations, mechanisms of action, and future prospects. FEMS Microbiol. Ecol. 2007, 61, 197–213. [Google Scholar] [CrossRef]
- Moosavi, M.R. Potential of soil amendment with organic matters in controlling phytonematodes. In New and Future Developments in Microbial Biotechnology and Bioengineering; Elsevier: Cambridge, MA, USA, 2022; pp. 315–344. [Google Scholar]
- Mcsorley, R. Overview of organic amendments for management of plant-parasitic nematodes, with case studies from Florida. J. Nematol. 2011, 43, 69–81. [Google Scholar] [PubMed]
- Raaijmakers, J.M.; Paulitz, T.C.; Steinberg, C.; Alabouvette, C.; Moënne-Loccoz, Y. The rhizosphere: A playground and battlefield for soilborne pathogens and beneficial microorganisms. Plant Soil 2009, 321, 341–361. [Google Scholar] [CrossRef]
- Febri, D.; Anizan, I.; Che, R.; Wan, N.; Abidah, A.; Eka, S.; Wan, M. Enhanced rice seedling growth by Clostridium and Pseudomonas. Biotechnology 2014, 13, 186–189. [Google Scholar]
- Num, S.M.; Useh, N.M. Clostridium: Pathogenic roles, industrial uses and medicinal prospects of natural products as ameliorative agents against pathogenic species. Jordan J. Biol. Sci. 2014, 7, 81–94. [Google Scholar]
- Khabbaz, S.E.; Ladhalakshmi, D.; Babu, M.; Kandan, A.; Ramamoorthy, V.; Saravanakumar, D.; Al-Mughrabi, T.; Kandasamy, S. Plant Growth Promoting Bacteria (PGPB)—A versatile tool for plant health management. Pest Manag. Sci. 2019, 1, 1–25. [Google Scholar] [CrossRef]
- Ueki, A.; Takehara, T.; Ishioka, G.; Kaku, N.; Ueki, K. Production of β-1, 3-glucanase and chitosanase from clostridial strains isolated from the soil subjected to biological disinfestation. AMB Express 2019, 9, 114. [Google Scholar] [CrossRef] [PubMed]
- Zhou, Y.; Chen, J.; Zhu, X.; Wang, Y.; Liu, X.; Fan, H.; Duan, Y.; Chen, L. Efficacy of Bacillus megaterium strain Sneb207 against soybean cyst nematode (Heterodera glycines) in soybean. Pest Manag. Sci. 2021, 77, 568–576. [Google Scholar] [CrossRef] [PubMed]
- Gerhart, P.; Murray, R.; Costilow, R.; Nester, E.; Wood, W.; Krieg, R.; Philips, G. Manual of Methods for Gen. Bacteriol; American Society for Microbiolology: Washington, DC, USA, 1981. [Google Scholar]
- Sambrook, J.; Fritsch, E.F.; Maniatis, T. Molecular Cloning: A Laboratory Manual; Cold Spring Harbor Laboratory Press: Cold Spring Harbor, NY, USA, 1989. [Google Scholar]
- Zhao, J.; Liu, D.; Wang, Y.; Zhu, X.; Xuan, Y.; Liu, X.; Fan, H.; Chen, L.; Duan, Y. Biocontrol potential of Microbacterium maritypicum Sneb159 against Heterodera glycines. Pest Manag. Sci. 2019, 75, 3381–3391. [Google Scholar] [CrossRef]
- Edwards, U.; Rogall, T.; Blöcker, H.; Emde, M.; Böttger, E.C. Isolation and direct complete nucleotide determination of entire genes. Characterization of a gene coding for 16S ribosomal RNA. Nucleic Acids Res. 1989, 17, 7843–7853. [Google Scholar] [CrossRef]
- Lane, D.J. 16S/23S rRNA Sequencing; John Wiley and Sons: Chichester, UK, 1991; pp. 115–175. [Google Scholar]
- Thompson, J.D.; Gibson, T.J.; Higgins, D.G. Multiple sequence alignment using ClustalW and ClustalX. Curr. Protoc. Bioinform. 2002, 2, 1–22. [Google Scholar] [CrossRef]
- Kumar, S.; Stecher, G.; Tamura, K. MEGA7: Molecular evolutionary genetics analysis version 7.0 for bigger datasets. Mol. Biol. Evol. 2016, 33, 1870–1874. [Google Scholar] [CrossRef] [PubMed]
- Hosseini, P.; Matthews, B.F. Regulatory interplay between soybean root and soybean cyst nematode during a resistant and susceptible reaction. BMC Plant Biol. 2014, 14, 300. [Google Scholar] [CrossRef] [PubMed]
- Abdul-Baki, A.A.; Anderson, J.D. Vigor determination in soybean seed by multiple criteria 1. Crop Sci. 1973, 13, 630–633. [Google Scholar] [CrossRef]
- Adam, M.; Heuer, H.; Hallmann, J. Bacterial antagonists of fungal pathogens also control root-knot nematodes by induced systemic resistance of tomato plants. PLoS ONE 2014, 9, e90402. [Google Scholar] [CrossRef]
- Barker, K. Design of Greenhouse and Microplot Experiments for Evaluation of Plant Resistance to Nematodes; University of Massachusetts Agricultural Experiment Station: Amherst, MA, USA, 1985; pp. 103–113. [Google Scholar]
- Yao, X.; Zhang, Q.; Fan, Y.; Xu, X.; Liu, Z. Butanol–isopropanol fermentation with oxygen-tolerant Clostridium beijerinckii XH29. AMB Express 2022, 12, 57. [Google Scholar] [CrossRef]
- Narueworanon, P.; Laopaiboon, L.; Laopaiboon, P. Capability of immobilized Clostridium beijerinckii TISTR 1461 on lotus stalk pieces to produce butanol from sugarcane molasses. Processes 2021, 9, 573. [Google Scholar] [CrossRef]
- Doni, F.; Al-Shorgani, N.K.N.; Abuelhassan, N.N.; Isahak, A.; Zain, C.R.C.M.; Yusoff, W.M.W. Microbial involvement in growth of paddy. Curr. Res. J. Biol. Sci. 2013, 5, 285–290. [Google Scholar] [CrossRef]
- Dong, H.; Zhang, Y.; Dai, Z.; Li, Y. Engineering Clostridium strain to accept unmethylated DNA. PLoS ONE 2010, 5, e9038. [Google Scholar] [CrossRef] [PubMed]
- Makut, M.; Obiekezie, S.; Owuna, G. Isolation and screening of biobutanol producing Clostridium species from the soil environment of Keffi Metropolis. South Asian J. Res. Microbiol. 2018, 1, 1–6. [Google Scholar] [CrossRef]
- Ueki, A.; Takehara, T.; Ishioka, G.; Kaku, N.; Ueki, K. Degradation of the fungal cell wall by clostridial strains isolated from soil subjected to biological soil disinfestation and biocontrol of Fusarium wilt disease of spinach. Appl. Microbiol. Biotechnol. 2017, 101, 8267–8277. [Google Scholar] [CrossRef]
- Tyagi, S.; Kumar, R.; Saharan, B.; Nadda, A.K. Plant-Microbial Interactions and Smart Agricultural Biotechnology; CRC Press: Boca Raton, FL, USA, 2021. [Google Scholar]
- Aioub, A.A.; Elesawy, A.E.; Ammar, E.E. Plant growth promoting rhizobacteria (PGPR) and their role in plant-parasitic nematodes control: A fresh look at an old issue. J. Plant Dis. Prot. 2022, 129, 1305–1321. [Google Scholar] [CrossRef]
- Cheng, W.; Yang, X.; Xue, H.; Huang, D.; Cai, M.; Huang, F.; Zheng, L.; Yu, Z.; Zhang, J. Reproductive toxicity of furfural acetone in Meloidogyne incognita and Caenorhabditis elegans. Cells 2022, 11, 401. [Google Scholar] [CrossRef]
- Ji, X.; Li, J.; Dong, B.; Zhang, H.; Zhang, S.; Qiao, K. Evaluation of fluopyram for southern root-knot nematode management in tomato production in China. Crop Prot. 2019, 122, 84–89. [Google Scholar] [CrossRef]
- Lahlali, R.; Ezrari, S.; Radouane, N.; Kenfaoui, J.; Esmaeel, Q.; El Hamss, H.; Belabess, Z.; Barka, E.A. Biological control of plant pathogens: A global perspective. Microorganisms 2022, 10, 596. [Google Scholar] [CrossRef]
- Migunova, V.D.; Sasanelli, N. Bacteria as biocontrol tool against phytoparasitic nematodes. Plants 2021, 10, 389. [Google Scholar] [CrossRef] [PubMed]
- Mitra, D.; Mondal, R.; Khoshru, B.; Shadangi, S.; Mohapatra, P.K.D.; Panneerselvam, P. Rhizobacteria mediated seed bio-priming triggers the resistance and plant growth for sustainable crop production. Curr. Res. Microb. Sci. 2021, 2, 100071. [Google Scholar] [CrossRef] [PubMed]
- Backer, R.; Rokem, J.S.; Ilangumaran, G.; Lamont, J.; Praslickova, D.; Ricci, E.; Subramanian, S.; Smith, D.L. Plant growth-promoting rhizobacteria: Context, mechanisms of action, and roadmap to commercialization of biostimulants for sustainable agriculture. Front. Plant Sci. 2018, 9, 1473. [Google Scholar] [CrossRef]
- Rizvi, A.; Ahmed, B.; Khan, M.S.; El-Beltagi, H.S.; Umar, S.; Lee, J. Bioprospecting plant growth promoting rhizobacteria for enhancing the biological properties and phytochemical composition of medicinally important crops. Molecules 2022, 27, 1407. [Google Scholar] [CrossRef] [PubMed]
- Devindrappa, M.; Kamra, A.; Grover, M.; Gawade, B. Nematicidal rhizobacteria with plant growth-promoting traits associated with tomato in root-knot infested polyhouses. Egypt. J. Biol. Pest Control 2022, 32, 51. [Google Scholar] [CrossRef]
- Messa, V.; Nunes, J.; Mattei, D. Seed Treatment with Bacillus amyloliquefaciens for the control of Meloidogyne javanica “in vivo” bean culture and its direct effect on the motility, mortality and hatching of M. javanica “in vitro”. Agron. Sci. Biotechnol. 2019, 5, 59. [Google Scholar] [CrossRef]
- Subedi, P.; Gattoni, K.; Liu, W.; Lawrence, K.S.; Park, S.-W. Current utility of plant growth-promoting rhizobacteria as biological control agents towards plant-parasitic nematodes. Plants 2020, 9, 1167. [Google Scholar] [CrossRef] [PubMed]
- El-Mageed, A.; Taia, A.; El-Mageed, A.; Shimaa, A.; El-Saadony, M.T.; Abdelaziz, S.; Abdou, N.M. Plant growth-promoting rhizobacteria improve growth, morph-physiological responses, water productivity, and yield of rice plants under full and deficit drip irrigation. Rice 2022, 15, 16. [Google Scholar] [CrossRef] [PubMed]

| Treatments | J2 Mortality (%) | Egg Hatchability (%) |
|---|---|---|
| CK | 0.99 ± 1.36 a | 29.07 ± 3.42 f |
| Sneb518 | 90.73 ± 0.74 b | 6.00 ± 1.94 a |
| Sneb528 | 83.75 ± 5.10 c | 11.20 ± 1.19 cd |
| Sneb532 | 86.54 ± 6.76 d | 6.40 ± 1.21 a |
| Sneb549 | 87.87 ± 7.77 c | 7.60 ± 1.80 ab |
| Sneb562 | 75.91 ± 6.83 de | 8.00 ± 1.05 ab |
| Sneb576 | 77.29 ± 4.81 ef | 13.20 ± 2.76 de |
| Sneb596 | 81.30 ± 8.59 c | 7.87 ± 1.59 ab |
| Sneb633 | 81.60 ± 3.23 de | 7.60 ± 2.79 ab |
| Sneb676 | 83.67 ± 4.68 f | 11.20 ± 2.02 cd |
| Sneb687 | 82.68 ± 4.76 e | 9.60 ± 1.21 bc |
| Sneb737 | 74.37 ± 2.38 d | 14.13 ± 1.73 e |
| Treatments | J2 Mortality (%) | Egg Hatchability (%) | ||||
|---|---|---|---|---|---|---|
| 24 h | 48 h | 72 h | 48 h | 72 h | 96 | |
| CK | 1.34 ± 1.59 b | 3.47 ± 3.02 b | 5.51 ± 3.11 b | 58.93 ± 2.67 a | 66.72 ± 3.78 a | 82.47 ± 2.71 a |
| Sneb518 | 91.55 ± 1.06 a | 93.99 ± 0.87 a | 96.00 ± 1.16 a | 10.27 ± 1.80 b | 16.42 ± 3.21 b | 24.12 ± 4.34 b |
| Treatments | Germination Rate | Shoot Length | Root Length | Seed Vigor Index |
|---|---|---|---|---|
| CK | 82.75 ± 3.89 b | 5.73 ± 0.46 a | 4.87 ± 0.50 a | 8.77 ± 1.03 b |
| Sneb518 | 88.49 ± 3.03 a | 6.50 ± 0.50 a | 5.80 ± 0.26 a | 13.90 ± 2.08 a |
| Treatments | Plant Length (cm) | Root Length (cm) | Root Dry Weight (g) | Root Fresh Weight (g) | Gall Index (%) | Biocontrol Efficacy (%) |
|---|---|---|---|---|---|---|
| CK+J2 | 34.82 ± 3.45 b | 15.72 ± 1.14 b | 0.31 ± 0.05 b | 2.66 ± 0.31 b | 77.2 b | - |
| Sneb518+J2 | 37.06 ± 3.19 a | 16.50 ± 0.75 a | 0.34 ± 0.05 ab | 2.85 ± 0.09 a | 38.4 a | 50.26 |
Publisher’s Note: MDPI stays neutral with regard to jurisdictional claims in published maps and institutional affiliations. |
© 2022 by the authors. Licensee MDPI, Basel, Switzerland. This article is an open access article distributed under the terms and conditions of the Creative Commons Attribution (CC BY) license (https://creativecommons.org/licenses/by/4.0/).
Share and Cite
Lian, X.; Liu, S.; Jiang, L.; Bai, X.; Wang, Y. Isolation and Characterization of Novel Biological Control Agent Clostridium beijerinckii against Meloidogyne incognita. Biology 2022, 11, 1724. https://doi.org/10.3390/biology11121724
Lian X, Liu S, Jiang L, Bai X, Wang Y. Isolation and Characterization of Novel Biological Control Agent Clostridium beijerinckii against Meloidogyne incognita. Biology. 2022; 11(12):1724. https://doi.org/10.3390/biology11121724
Chicago/Turabian StyleLian, Xinglong, Shuang Liu, Lanyuwen Jiang, Xinyu Bai, and Yuanyuan Wang. 2022. "Isolation and Characterization of Novel Biological Control Agent Clostridium beijerinckii against Meloidogyne incognita" Biology 11, no. 12: 1724. https://doi.org/10.3390/biology11121724
APA StyleLian, X., Liu, S., Jiang, L., Bai, X., & Wang, Y. (2022). Isolation and Characterization of Novel Biological Control Agent Clostridium beijerinckii against Meloidogyne incognita. Biology, 11(12), 1724. https://doi.org/10.3390/biology11121724

